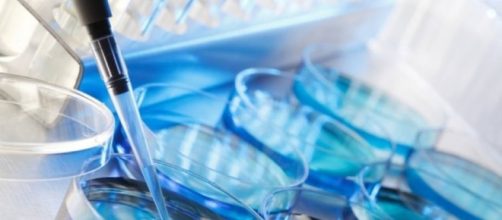
El virus del Zika como herramienta frente al c&aacute;ncer cerebral

El agente patógeno
El virus del Zika (ZIKV) es un Flavivirus originario de África, su nombre deriva de su primera descripción en el bosque Zika de Uganda en 1947, y presente en toda la franja ecuatorial mundial. En el año 2014 el virus comenzó su expansión hacia el este, llegando al continente americano en el año 2015 y estando muy extendido por América Central y del Sur en 2016. Esta rápida dispersión es debida a su transmisión mediante insectos vectores, que son mosquitos del género Aedes, también transmisores de otras enfermedades como la fiebre amarilla o el dengue.
La enfermedad se manifiesta generalmente de forma similar a una gripe, con fiebre, dolor de cabeza, malestar general, dolores articulares, e incluyendo conjuntivitis y sarpullidos. Esta sintomatología no representa una enfermedad realmente grave, pues los síntomas remiten fácilmente con el uso de analgésicos y la afectación es normalmente muy reducida en el 80% de la población. Pero más importantes son los casos registrados de microcefalia en recién nacidos cuyas madres habían sido infectadas por el virus durante los primeros tres meses de embarazo. La relación entre el virus y la microcefalia fue postulada por el Centro Europeo para la Prevención y Control de Enfermedades (ECDC), enfermedad que provoca una degeneración y malformación del Cerebro del bebe, que nace con una cabeza más pequeña de lo normal, e incluso puede llegar a morir.
No todo es malo
El gliobastoma es el nombre médico con el que se conoce a los tumores cerebrales, siendo el tipo de cáncer más común y maligno de los que pueden desarrollarse a partir del tejido nervioso. En este sentido, un grupo de investigadores de la Universidad de Campinas (Brasil) han observado como el virus del Zika ataca las células que conforman este tipo de tumores, al igual que lo hace a las células que están formando el cerebro del feto en desarrollo. En el estudio se han infectado in vitro (dentro de material de laboratorio, con ambiente controlado) células del gliobastoma maligno humano con el virus, observando como a las 48 horas comienza la muerte de las células tumorales.
Posteriormente, analizaron los compuestos que se acumulaban en estas células tumorales durante la infección con el virus, comprobando como ocurría la acumulación de un glucósido cardíaco denominado digoxina, que ya había sido descrito como potente agente en el tratamiento del cáncer de piel y de mama.
Por lo tanto, los investigadores piensan que la infección con el virus provoca la acumulación de digoxina en estas células, siendo esta molécula la que causa su muerte. En un futuro, modificar genéticamente al virus para que no sea patógeno y simplemente sintetice digoxina podría ser una alternativa muy buena contra el glioblastoma, cáncer muy resistente frente a la quimioterapia.
“La ciencia que no es divulgada hacia la sociedad es como si no existiera”